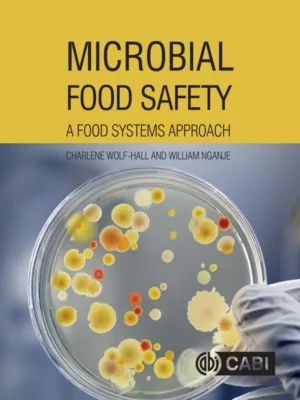
دانلود pdf کتاب ایمنی میکروبی غذا: رویکردی به سیستمهای غذایی

سایت برتر ترجمه کتاب دامپزشکی
به بلید، سایت برتر ترجمه کتاب دامپزشکی خوش آمدید. اگر به ترجمه کتاب دامپزشکی نیاز دارید، خواهان تبدیل پایان نامه خود به کتاب هستید، قصد انتشار کتابی در حوزه دامپزشکی دارید، سانتر ترجمه کتاب دامپزشکی بلید آمادگی دارد کتاب شما را ترجمه و منتشر نماید. پایان نامه شما را تقویت کرده و در قالب کتاب حروفچینی و منتشر نماید. کافی است سفارش ترجمه کتاب خود را ثبت کنید. می توانید ایبوک مورد نظر خود را در کادر جستجوی زیر پیدا کنید.
نمایش 1–12 از 515 نتیجهمرتبسازی بر اساس جدیدترین
-

کتاب تکنیکهای ایمنی و نگهداری میکروبی مواد غذایی
450000 ریالافزودن به سبد خرید -

کتاب تکنیکهای نوین نگهداری و ارزیابی میکروبی مواد غذایی
400000 ریالافزودن به سبد خرید -

کتاب میکروبیولوژی غذایی مدرن
500000 ریالافزودن به سبد خرید -

کتاب داروهای ضدمیکروب آینده از محصولات طبیعی
500000 ریالافزودن به سبد خرید -

کتاب بیماری های غذا زی
500000 ریالافزودن به سبد خرید -

درسنامه بیماری های منتقله از غذا با منشاء بیولوژیک CRC
450000 ریالافزودن به سبد خرید -

کتاب تکنیکهای اندازه گیری ایمنی و کیفیت مواد غذایی
450000 ریالافزودن به سبد خرید -

کتاب ضد میکروبها برای ذخیره پایدار مواد غذایی
600000 ریالافزودن به سبد خرید -
کتاب ایمنی میکروبی غذا
500000 ریالافزودن به سبد خرید -

کتاب ایمنی جهانی غذا: مداخلات میکروبی و پیشرفتهای ملکولی
550000 ریالافزودن به سبد خرید -

کتاب اعتبارسنجی فرآیندهای نگهداری مواد غذایی برپایه فناوریهای نوین
500000 ریالافزودن به سبد خرید -

کتاب ضدمیکروبها در علم و فناوری غذایی
650000 ریالافزودن به سبد خرید
